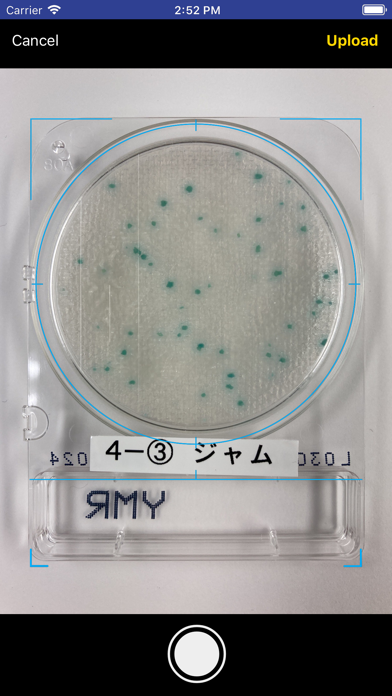

@BactLAB
2.0.4
Shimadzu Diagnostics Corporation
1.67
6 reviews
Free
Not recently updated — last update was on 2023-10-03.
This app may no longer be actively maintained.
About @BactLAB
@BactLAB is an overall app developed by Shimadzu Diagnostics Corporation.
How many times has @BactLAB been downloaded?
What is the rating of @BactLAB?
@BactLAB is rated 1.67 out of 5 stars, based on 6 ratings.
Is @BactLAB free?
@BactLAB is free to download. The APK download size is 17.81 MB. The latest version available is 2.0.4. The last update was on October 3, 2023.
What are the requirements for @BactLAB?
The app has a content rating of Medium Maturity. The app has been available on Google Play August 2018.
Description
More data about @BactLAB
| Price | Free to download |
| Rating | 1.67 based on 6 ratings |
| Ranking | Not ranked |
| Version | 2.0.4 |
| App download size | 17.8 MB |
| Maturity | Medium Maturity |
Alternative downloads for the @BactLAB app
Changelog of @BactLAB
No changelog data
Developer information for Shimadzu Diagnostics Corporation
Shimadzu Diagnostics Corporation
Address:
Comments on @BactLAB for iOS
We don't have enough comments to show example comments. Please check back later.
App Store Rankings for @BactLAB
This app is not ranked
Technologies used by @BactLAB
Back to top